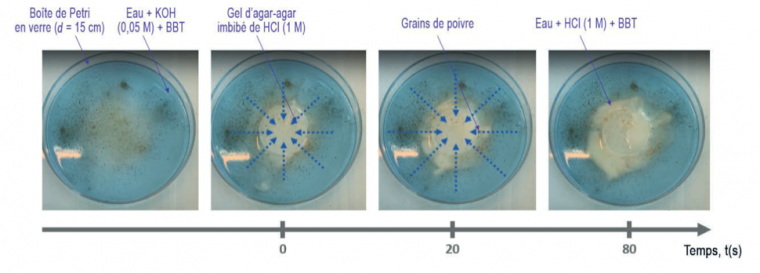

Cette revue de presse est le fruit des lectures de collègues :
Amandine Vincent (Le BUP), Françoise Brénon (Médiachimie) et Sylvain Clède (l’Actualité Chimique). Nous vous souhaitons une bonne lecture !
Le BUP — février 2023
Poivre peureux, poivre heureux
Le BUP, février 2023, p. 149-165
J. Piard, B. Boulenger, E. Brudy, C. Dubois, A. Eisenbeth, L. Barreau
L’expérience dite du « poivre heureux » ou du « poivre magique » sur laquelle s’appuie l’article est la suivante : du poivre déposé à la surface de l’eau est repoussé sur les bords du récipient lorsqu’une pointe de savon est ajoutée. Le phénomène s’explique ainsi : l’ajout de savon permet d’abaisser, à l’endroit où il est déposé, la tension superficielle grâce aux tensioactifs qu’il contient. Le gradient de concentration en tensioactifs à la surface eau-air causé par l’ajout de savon crée donc un gradient de tension superficielle. Le déplacement des grains de poivre vers le bord du récipient s’explique alors par l’écoulement de Marangoni du centre (basse tension superficielle) vers les bords du récipient (haute tension superficielle).
Comment faire en sorte que le poivre ait un mouvement inverse, c’est-à-dire se déplace de l’extérieur du récipient vers le centre ? Autrement dit, comment rendre le poivre « heureux » ? C’est le défi qui a été posé dans le cadre du tournoi des chimistes en mars 2022 dans lequel s’affronte plusieurs grandes écoles dont l’ENS Paris-Saclay.
Il faut ainsi inverser le gradient de tension superficielle par rapport à l’expérience de poivre peureux. Une première idée consiste à déposer le savon sur les bords du verre et non pas au centre (inversion du gradient de concentration en tensioactif et donc en tension superficielle). Les résultats sont concluants. Une seconde proposition est de réaliser un gradient de température. Les zones froides, présentant une agitation thermique moindre, stabilisent les molécules en surface ce qui conduit à une diminution de la tension superficielle par rapport aux zones plus chaudes. Une relation affine existe entre tension superficielle et température. Pour des raisons techniques, l’étude est faite non pas avec de l’eau mais avec de l’huile. Le gradient est réalisé en introduisant un glaçon d’huile d’olive au centre d’une boite de Pétri, celui-ci baignant dans une huile d’olive à 50°C.
La mise en place du gradient de température (durant environ 3 min) est suivie par caméra thermique et modélisée avec Python à partir de l’équation de la chaleur.
Une dernière expérience est menée avec un gradient de pH. À bas pH, les tensioactifs sont protonés et les interactions intermoléculaires sont différentes de celles à pH plus élevé, provoquant une disposition non régulière de ces derniers à la surface liquide-air qui a pour effet d’augmenter la tension superficielle. Pour réaliser le gradient en pH (établi durant une dizaine de seconde), un gel d’agar-agar acidifié est placé au centre d’une boîte à Pétri. Ce gel est entouré d’une solution basique. Du bleu de bromothymol est ajouté pour visualiser le gradient de pH.
Détermination de la concentration micellaire critique d’une solution aqueuse de dodécylsulfate de sodium en présence d’alcools par conductimétrie
Le BUP, février 2023, p. 167-171.
B. Devallez, L. Solé-Violán
Cet article fait suite à celui d’octobre 2022. Les auteurs déterminent des valeurs de concentration micellaire critique (cmc) par conductimétrie d’un tensioactif bien connu (le dodécylsulfate de sodium) dans de l’eau et dans des solutions aqueuses contenant des alcools allant d’un à trois atomes de carbone. Le recours fréquent au dodécylsulfate avec des alcools en cosmétique justifie l’intérêt de cette étude.
On note un abaissement de la cmc en présence d’alcool. Cette diminution s’accroit avec la longueur de la chaîne de l’alcool (pour des alcools linéaires). Ceci s’explique par deux facteurs. Le premier consiste à dire que l’ajout d’alcool a tendance à diminuer la permittivité diélectrique relative de l’eau. Ainsi la répulsion entre les parties anioniques du tensioactif diminue et la formation de micelle est facilitée. L’autre explication du phénomène vient du fait que l’ajout d’alcool renforce les interactions hydrophobes au sein des micelles en s’intercalant entre les molécules de dodécylsulfate (au niveau de la partie hydrophile) comme représenté sur la figure ci-contre. Ainsi la cmc est plus faible pour un alcool secondaire qu’un alcool primaire de même nombre d’atomes de carbone.
L’acide β-cyclocitrique, un phytostimulant naturel pour protéger les plantes de la sécheresse
Le BUP, février 2023, p. 191-195.
S. D’alessandro, M. Havaux
Le BUP publie ici un article de biochimie. Les auteurs présentent les bienfaits d’un phytostimulant : l’acide β-cyclocitrique jouant un rôle dans la protection des plantes contre la sécheresse. Les résultats sont prometteurs et les études ont été brevetées. Naturellement, l’acide β-cyclocitrique est produit par la plante par oxydation du β-cyclocitral lui-même issu du β-carotène. Sa production permet à la plante de résister à un stress environnemental tel que la sécheresse. Plus exactement, sa production est accrue (passage de 0,3 μM jusqu’à 1 μM) lorsqu’il y a un déséquilibre entre les éléments permettant à la plante de pousser : ici entre le taux de lumière absorbé et l’eau présente dans les sols. Un arrosage des plantes par ce phytostimulant en amont du stress hydrique permet à la plante une meilleure acclimatation et résistance à la sécheresse.
L’Actualité Chimique — mars et avril 2023
L’utilisation des chélateurs et complexes de cuivre en biologie et en médecine
Actualité Chimique, mars 2023, p. 12-17.
P. Faller
Un article détaillé sur le rôle du cuivre en biologie, principalement disponible sous forme de complexes centrés sur Cu(+I) ou Cu(+II). On y apprend notamment que le cuivre extracellulaire (comme dans le sang) est essentiellement sous forme Cu(+II) mais qu’il est majoritairement à l’état cuivre (+I) dans les cellules, en raison de la forte concentration en fonctions thiol réductrices. Des schémas simplifiés permettent de comprendre le métabolisme du cuivre chez un individu sain ou atteint d’une maladie liée à ce métal. Les deux états rédox du cuivre ayant une géométrie de coordination très différente, il est assez aisé de synthétiser des ligands sélectifs de l’un ou l’autre de ces deux états. Des tableaux comparatifs des propriétés des systèmes Cu(+I)-L ou Cu(+II)-L peut permettre l’élaboration d’un sujet sur les complexes de métaux de transition en chimie bioinorganique.
Le sens caché des fausses couleurs de l’hydrogène
Actualité Chimique, avril 2023, p. 8-10.
B. Valeur
Le dihydrogène, gaz incolore, se voit affublé de nombreuses fausses couleurs en lien avec son mode d’obtention plus ou moins respectueux de l’environnement.
L’auteur décrypte de façon claire et précise ce code couleur permettant d’apprécier l’empreinte carbone des divers procédés de production du dihydrogène.
Théorie et simulations de processus ultra-rapides en photochimie
Actualité Chimique, avril 2023, p. 22-28.
F. Agostini
Un document riche où l’on appréciera l’exposé didactique de l’autrice, qui décrit des processus photochimiques, depuis l’excitation initiale jusqu’à une éventuelle réaction ultra-rapide ou une émission de fluorescence. Toute la première partie peut ainsi constituer un document permettant aux élèves de découvrir les principaux processus photo-induits, dont les temps caractéristiques sont fournis. Le texte illustre ensuite différents exemples de devenirs photochimiques, comme celui du rétinal ou de l’oxirane.
Croyances et expériences : la loi de Beer-Lambert n’est valable que pour une absorbance inférieure à 1
Actualité Chimique, avril 2023, p. 31-40.
J. Piard, C. Doré
Les auteurs s’attachent à déconstruire une croyance profondément ancrée dans les esprits : la loi de Beer-Lambert ne serait plus applicable lorsque l’absorbance dépasse la valeur de 1. La distinction entre limites fondamentale et instrumentale est établie, cette dernière étant la cause principale d’un écart à la linéarité dans le tracé de A = f(C). Notamment la sensibilité de détection du spectrophotomètre, le taux de lumière parasite et le courant d’obscurité (réponse du détecteur en l’absence de rayonnement) sont à l’origine de cette perte de linéarité. Cette étude exhaustive peut nous permettre d’introduire ces notions à nos étudiant.e.s et de les sensibiliser à la mesure et ses limites instrumentales.
Médiachimie
Les dernières nouveautés du site Mediachimie pouvant intéresser les enseignants de classes préparatoires sont :
- La question du mois :
Avec quels matériaux sont fabriquées les éoliennes et comment les recycler ?
Ressource qui apporte de nombreuses informations sur les différents types d'éoliennes, les matériaux, leur recyclage et les recherche en cours.
- Du nouveau dans la rubrique des « ZOOM SUR… » regroupés ici :
Les traitements des cancers : petites ou grosses molécules ?, par JP Foulon
Les principales stratégies utilisées dans le traitement des cancers et les molécules utilisées dans la chimiothérapie, les thérapies ciblées, l’immunothérapie et les immunoconjugués sont abordées.
ZOOM sur les progrès de l’optoélectronique : des LED aux OLED, par JP Foulon
Pour en savoir plus sur les matériaux organiques constituants les multicouches des OLED et le passage aux monocouches des SL-OLED puis aux SL-PhOLED avec émetteur phosphorescent.
- Dans la rubrique HISTOIRE DE LA CHIMIE, deux anecdotes relatives à la métallurgie au XVIIIe siècle:
L’étonnante Gloriette de Buffon au Jardin des Plantes, l’une des premières constructions métalliques au monde, par B. Bodo
Histoire de sa construction et des remises en état nécessaires en raison de la corrosion : un bel exemple pour illustrer les cours sur la corrosion liée à l’association de métaux différents.
Des voyages métallurgiques au XVIIIe siècle, par C. Marchal
Pour découvrir Gabriel Jars le Jeune, métallurgiste, créateur de la sidérurgie française et aussi innovateur en introduisant des nouveaux procédés.